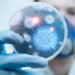

Türkiye Futbol Federasyonu (TFF) tarafından verilen Fair Play Ödülleri’nde Mart 2024 kazananları açıklandı.
Federasyondan yapılan açıklamaya göre, TFF’nin sporun vazgeçilmez unsuru olan fair play’in yaygınlaştırılması ve farkındalık oluşturulması amacıyla düzenlediği ödüllerin Mart 2024 dönemi sahipleri belli oldu.
Başkan Ali Erten, Prof. Dr. Mustafa Sait Gönen, Prof. Dr. Burhanettin Hacıcaferoğlu, Prof. Dr. Fatma Ayanoğlu, Banu Yelkovan, Attila Gökçe, Ömer Üründül, Berrin Altınöz ve Metin Tekin’in yer aldığı TFF Fair Play ve Sosyal Sorumluluk Kurulu, gerçekleştirdiği toplantıyla ödül alacak isimleri belirledi.
ÖDÜL ALANLAR VE GEREKÇELERİ
Kurulun değerlendirmesi sonucunda en centilmen teknik direktör ve en centilmen futbolcu kategorilerinde ödüle layık görülenler ve verilme gerekçeleri şöyle:
EN CENTİLMEN TEKNİK DİREKTÖR: SAMİ UĞURLU (KASIMPAŞA)
Gerekçe: Trendyol Süper Lig’de 17 Mart 2024 tarihinde oynanan Kasımpaşa-Galatasaray maçı sonrasında, ‘Futbolcularıma ayakta kalmayı, düşmemeyi söylüyorum. Tempo futbolu güzelleştiriyor. Bunun da ödüllendirilmesi lazım. Kaybettik ama keyifliyiz. Çünkü çok iyi oynadık, biz oynadığımız futboldan keyif alıyoruz. Galatasaray’ı da tebrik ediyorum.’ şeklindeki oyundan süre çalmanın fair play’e aykırı olduğunu hatırlatan, rakibe, izleyicilere ve stadyumu dolduran futbolseverlere saygının da oyunun bir parçası olduğunun altını çizen açıklamasıyla Mart 2024 ayının ‘En Centilmen Teknik Direktörü’ seçilmiştir.
EN CENTİLMEN FUTBOLCU: SOKOL CİKALLESHİ (TÜMOSAN KONYASPOR)
Gerekçe: Trendyol Süper Lig’de 9 Mart 2024 tarihinde Konya’da oynanan TÜMOSAN Konyaspor-Adana Demirspor karşılaşmasında, Konyaspor futbolcusu Sokol Cikalleshi’nin, takımının hücumu sırasında, rakibi Gravillon’un istemeyerek eline bastığını fark ettikten sonra takımının atağına katılmayarak sakatlanan rakibinin başında beklemesi ve maç sonrasında yaptığı, ‘Atağa çıkarken elinin üstüne bastığımı düşünüyorum. Bundan dolayı bir çığlık duydum. Burada oyundan ziyade insan ve hümanist olmak çok daha önemli. Onun sağlığı için onunla orada durdum. Bu anı onunla paylaştım. Bu durumda gol atsam da benim için mutlu bir hissiyat değil.’ şeklindeki fair play değerlerini yücelten açıklamaları için bu oyuncu kurul üyeleri tarafından Mart 2024 ayının “En Centilmen Futbolcusu” olarak seçilmiştir.
Kaynak: AA
***Mutluluk, adalet, özgürlük, hukuk, insanlık ve sevgi paylaştıkça artar***